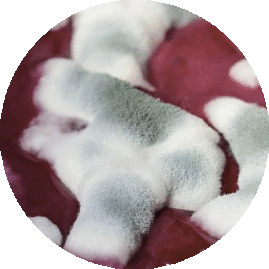

W 2013 r. amerykańskie Centrum Kontroli i Prewencji Chorób (Centers for Disease Control and Prevention, CDC) podało listę antybiotykoopornych bakterii. Pojawiły się na niej:

Szacuje się, że samych gatunków bakterii bytujących w glebie, odpowiadających tam za obieg węgla i składników odżywczych, jest na świecie milion milionów!
- Clostridium difficile (wywołuje rzekomobłoniaste zapalenie jelit);
- oporne na karbapen enterobakterie, CRE (zakażenia dróg moczowych, układu oddechowego, krwi);
- lekooporna dwoinka rzeżączki (rzeżączka, gonokokowe zapalenie spojówek u niemowląt);
- wielolekooporne bakterie z rodzaju Acinetobacter (zakażenia płuc, skóry, układu moczowego i nerwowego);
- lekooporne bakterie z rodzaju Campylobacter (zakażenia układu pokarmowego);
- wiele szczepów Enterobacteriaceae produkujących β-laktamazy (warunkują odporność bakterii na antybiotyki);
- odporne na wankomycynę enterokoki, VRE (sepsa);
- wielolekooporna pałeczka ropy błękitnej (zapalenie opon mózgowo-rdzeniowych, zakażenia układu moczowego, kości, oczu, uszu i układu oddechowego;
- nietyfusowa lekooporna Salmonella (zatrucia pokarmowe);
- tyfusowa lekooporna Salmonella (dur brzuszny);
- oporny na metycylinę gronkowiec złocisty, MRSA (zastrzał, zanokcica, ropne zapalenie mózgu, zakażenia pooperacyjne);
- lekooporna dwoinka zapalenia płuc (zapalenie płuc, zapalenie zatok, zapalenie ucha środkowego, ropień mózgu);
- lekooporny prątek gruźlicy (gruźlica)1.
Oznacza to, że zwalczanie chorób wywołanych przez te bakterie będzie coraz trudniejsze. Ponadto w każdej chwili mogą pojawić się nowe szczepy, które zyskały oporność na antybiotyki. Czym to wytłumaczyć?
Oporność drobnoustrojów na antybiotyki wynika w głównej mierze z tego, że leki te są przez nas stosowane w nadmiernych ilościach. Czym więc tak naprawdę są antybiotyki? Kiedy należy je stosować? Z jakimi zagrożeniami wiąże się antybiotykoterapia? Oto 10 faktów na temat naszej najsilniejszej, wydawałoby się, ochrony przeciw mikroorganizmom.
1. Oddziałują jak naturalna broń masowego rażenia
Antybiotyki to substancje wytwarzane przez organizmy jednokomórkowe skierowane przeciwko innym drobnoustrojom. Mechanizmy ich działania są różne: niszczą ściany komórkowe (atakowany mikroorganizm dosłownie rozpada się pod ich wpływem na części), uszkadzają DNA lub zaburzają procesy życiowe2. Dzięki wydzielanym przez siebie antybiotykom bakteria ma większe szanse na skolonizowanie biomu jelitowego, zdobycie odpowiedniej ilości pożywienia i - co się z tym wiąże - przetrwanie.
Te antybiotyki, w odróżnieniu od syntetycznych, są ukierunkowane na konkretne gatunki i nie działają na inne.
Antybiotyki odkrył przypadkiem w 1928 r. Alexander Fleming. Niechcący dopuścił do zanieczyszczenia próbki bakteryjnej pleśnią, która - jak się później okazało - uniemożliwiła bakteriom zasiedlenie pożywki. Produkowana przez tę pleśń penicylina stała się pierwszym antybiotykiem wykorzystywanym przez człowieka.
Wraz z odkryciem penicyliny ludzkość uzyskała kolejną (po szczepieniach) potężną broń w walce z chorobami, wywoływanymi przez drobnoustroje. Wydawało się, że to lekarstwo na wszystkie zakażenia. Tym niemniej jedna z groźniejszych obecnie bakterii, gronkowiec złocisty, okazała się na nie naturalnie odporna3.
2. Są nieskuteczne w przypadku wirusów
Kwestia przynależności wirusów do świata ożywionego nadal pozostaje sporna. Wprawdzie wykazują one wiele cech organizmów żywych (mają DNA lub RNA, są zdolne do ruchu i rozmnażania się), jednak nie oddychają i są nieaktywne, o ile nie znajdują się w sprzyjającym środowisku (wewnątrz organizmu jedno- lub wielokomórkowego).
A dlaczego antybiotyki są wobec nich bezradne? Wirusy nie wykazują własnego metabolizmu, który jest niezbędny do uaktywnienia mechanizmu działania tych leków, polegającego np. na hamowaniu syntezy białek niezbędnych bakteriom do przetrwania.
Wirusy wywołują m.in. wiele dobrze nam znanych i często występujących chorób, takich jak grypa, przeziębienie, ospa i nagminne zapalenie przyusznic (świnka). W przebiegu tych schorzeń przyjmowanie antybiotyków jest nieuzasadnione, a nawet niebezpieczne dla zdrowia: wyjałowiony z dobroczynnych bakterii organizm jest jeszcze bardziej osłabiany i trudniej wrócić wtedy do zdrowia.
3. Sprzyjają rozprzestrzenianiu się groźnych bakterii
Stosowane obecnie antybiotyki powstają w laboratorium i każdy z nich jest środkiem przeciwko kilku szczepom bakterii naraz. Wbrew pozorom nie jest to dobra wiadomość. Taka substancja nie działa wybiórczo, tylko niszczy na swojej drodze wszystko, co żywe. Również pożyteczne bakterie jelitowe, które pomagają nam trawić pokarm i wytwarzają niezbędne witaminy.
Dlatego tak ważne jest w czasie antybiotykoterapii przyjmowanie probiotyków. Zawarte w nich dobroczynne szczepy bakterii kwasu mlekowego uzupełnią szeregi naszych małych sprzymierzeńców, z których wielu niepotrzebnie poległo w walce z groźnym najeźdźcą.
Po probiotyki warto sięgnąć z jeszcze jednego powodu. Chorobotwórcze mikroorganizmy, które przetrwały kontakt z antybiotykami, mogą się teraz rozmnażać bez przeszkód - całe jelita należą do nich, nic nie hamuje ich rozrostu. I zgodnie z zasadą: co nie zabije, to wzmocni, stały się silniejsze. W efekcie takiego zaburzenia bioty jelitowej dają o sobie znać objawy przypominające zatrucie pokarmowe: biegunki, wymioty, ogólne osłabienie, odwodnienie... Biały nalot na języku to również znak, że w organizmie szaleją złowrogie bakterie4.
4. Wywołują.... antybiotykoodporność
Niektóre bakterie są naturalnie odporne na groźne substancje wytwarzane przez inne szczepy. Jednak od kilkunastu lat obserwuje się, że wiele z nich traci wrażliwość na kolejne związki czynne obecne w antybiotykach, co stanowi dla nas poważne zagrożenie. W dużej mierze sami jesteśmy temu winni, ponieważ przez całe dekady nadużywaliśmy antybiotykoterapii. Wiara w skuteczność tych leków doprowadziła do tego, że były często przepisywane przez lekarzy zupełnie niepotrzebnie. Zatkane zatoki? Antybiotyk. Ból gardła? Antybiotyk. Szybko, zanim rozwinie się coś poważniejszego!
Niektóre problemy zdrowotne mogą być wywoływane zarówno przez bakterie, jak i wirusy. Optymalnym rozwiązaniem byłoby pobranie w pierwszej kolejności próbki materiału do badania mikrobiologicznego, by ustalić przyczyny zakażenia, jak to ma już miejsce w wielu krajach Zachodu. Łatwiej jednak (i taniej) przepisać antybiotyk.
Grzechem pacjentów jest nieprzestrzeganie zaleceń lekarza i producenta farmaceutyku. Jeżeli chory został poinstruowany, jak długo ma przyjmować dany lek, to nie wolno mu go odstawić wcześniej, nawet jeśli poczuje się zdecydowanie lepiej. Przerwanie antybiotykoterapii sprawi, że nie wszystkie patogeny zostaną zniszczone, a te, które przeżyją, uodpornią się na lek. Również w przypadku wystąpienia działań niepożądanych należy skontaktować się z lekarzem, a nie samodzielnie zmniejszać dawkę leku5.
Jedną z metod walki bakterii z antybiotykami jest tzw. pompa effluks. To mechanizm polegający na "wypluwaniu" z wnętrza komórki substancji chemicznych zagrażających życiu bakterii6. Istnieją również geny odpowiedzialne za antybiotykooporność. Bakterie są w stanie przekazywać je sobie, tak jak studenci ściągi na egzaminie. Dzięki temu jeszcze szybciej uodparniają się na leki.
Prym w dzieleniu się takimi genami wiedzie, a jakżeby inaczej, gronkowiec złocisty, który jawi się jako nasz największy wróg w walce z antybiotykoopornymi bakteriami. Kiedy w latach 50. XX wieku w placówce medycznej Boston City Hospital zaczęto stosować erytromycynę, gronkowiec uodpornił się na nią w ciągu zaledwie kilku miesięcy3.
Czy to oznacza, że oporne na antybiotyki patogeny są niepokonane? Niekoniecznie. Czasem wystarczy zaaplikowanie większej dawki lub podanie silniejszego leku. Nie zmienia to faktu, że coraz częściej namnażają się tylko te drobnoustroje, które przeżyły kontakt z antybiotykiem.
5. Powodują zwiększenie masy mięśniowej
W 1946 r. odkryto, że streptomycyna podawana kurczętom w ramach profilaktyki chorób układu pokarmowego przyspiesza i zwiększa przyrost tkanki mięśniowej. Trzy lata później to samo zjawisko zaobserwowano w przypadku chlorotetracykliny (aureomycyny). Nie minęło dużo czasu, a antybiotyki stały się dodatkiem do pasz dla drobiu, bydła i trzody chlewnej.
Tak oto lekarstwa, które miały zapobiegać rozwojowi chorób, zmieniły się w preparaty umożliwiające hodowcom szybki zarobek - powodowały przyrost masy mięśniowej o 28% większy niż u osobników niekarmionych antybiotykami. W latach 60. i 70. XX wieku antybiotyki były już podawane zwierzętom w olbrzymich ilościach i pod każdym możliwym pretekstem7. Również pszczelarze sięgnęli po nie, aby zwalczać m.in. zakażenia paciorkowcami8.
Ale każdy medal ma dwie strony. Okazało się, że antybiotyki przenikają do mięsa i organów zwierząt, a tym samym są spożywane przez ludzi. U konsumentów pojawiły się reakcje alergiczne, problemy z jelitami, a na całym świecie odnotowywano gwałtowny wzrost liczby szczepów bakterii opornych na antybiotyki. Zanim jednak te informacje ujrzały światło dzienne, antybiotyki były już obecne we wszystkim, nawet w jajach, mleku i miodzie.
Obecnie ich stosowanie jest zabronione w krajach Unii Europejskiej. Jako pierwsza taki zakaz wprowadziła w 1986 r. Szwecja. Wciąż można jednak dodawać je do paszy w wielu innych krajach, np. w Stanach Zjednoczonych, Australii, Chinach i Rosji7.
6. Często prowadzą do groźnych powikłań zdrowotnych
Paradoksalnie, choć antybiotyki mają nam pomóc w odzyskaniu zdrowia, mogą wywoływać groźne powikłania, łącznie z takimi reakcjami alergicznymi jak świąd, wysypka, opuchlizna twarzy i języka oraz omdlenia4. Ponadto wyjaławiają jelita, zabijając wszystkie obecne w nich bakterie, również pożyteczne, które wytwarzają witaminę K oraz witaminy z grupy B.
Witamina K zwiększa przyswajalność witaminy D oraz wapnia, zapobiega powstawaniu ubytków w układzie kostnym. Witaminy z grupy B odpowiadają za zdrowie skóry, włosów i naczyń krwionośnych - ich niedobór prowadzi do zwiększonej podatności na siniaki, rozwoju anemii, problemów skórnych i wypadania włosów.
Oczywiście nie oznacza to, że zażywanie przez kilka dni antybiotyku od razu wywoła osteoporozę. Jednak długotrwała antybiotykoterapia nie pozostaje bez wpływu na funkcjonowanie całego organizmu.
7. Znajdują się dosłownie wszędzie...
Nawet w glebie czy wodzie - i to w statystycznie znaczących stężeniach. Do niedawna sądzono, że obecność antybiotyków w środowisku naturalnym to efekt karmienia nimi zwierząt hodowlanych. Dziś już wiemy, że lwia część tych leków przedostaje się do niego wraz z odpadami ze szpitali i zakładów produkujących farmaceutyki7. W dodatku każdy lek może wejść w interakcję z innym środkiem chemicznym, czyli powstają mieszanki o nikomu nieznanych właściwościach.
Obecnie nikt już nie wątpi, że odpady medyczne stanowią poważne zagrożenie dla ekosystemu i przyczyniają się do wzrostu oporności mikrobów9. Krótko mówiąc, ludzkość - nie do końca świadomie - podcina gałąź, na której siedzi.
8. Można je stosować w ciąży - pod pewnymi warunkami
Kobietom w ciąży odradza się picie alkoholu i przyjmowanie leków. Zdarzają się jednak sytuacje wymagające podania antybiotyku - co wtedy? Na szczęście natura przewidziała taką możliwość. Łożysko i pępowina pilnują, aby jak najmniej szkodliwych substancji przenikało do płodu. Jeśli więc przyszła mama będzie leczona np. penicyliną, to ten mechanizm powinien zadziałać.
Odradza się stosowanie antybiotyków w okresie tzw. organogenezy (14.-56. dzień ciąży), kiedy kształtują się narządy dziecka, oraz niedługo przed planowanym terminem rozwiązania - leki te mogą wywołać akcję porodową10.
A co z pierwszymi dwoma tygodniami istnienia embriona? Przecież wiele kobiet jeszcze wtedy nie wie, że jest w ciąży. Natura przewidziała i taką sytuację. Przyjmowane w tym okresie leki nie wpływają znacząco na rozwój zygoty.
W przypadku kobiet ciężarnych lekarze wykazują dużą ostrożność w doborze farmaceutyków. Dlatego jeśli już przepisano nam antybiotyk, bezwzględnie przyjmujmy go zgodnie z zaleceniami. W ten sposób nie tylko szybciej wrócimy do zdrowia, ale też zmniejszymy ryzyko jego oddziaływania na płód.
9. Są źródłem dochodów koncernów farmaceutycznych
Wartość globalnego rynku farmaceutycznego przyprawia o ból głowy. W 2012 r. było to 43,5 mld dolarów! I kwota ta wciąż rośnie! Szacuje się, że w 2019 r. wyniesie ponad 45 mld dolarów11.
A chęć zysku czasami nie zna granic. Zdarza się, że rządy poszczególnych krajów nie dopuszczają jakiegoś antybiotyku do obiegu lub też musi on zostać wycofany z aptek, bo jest już nieskuteczny. Co wtedy? Producenci często sprzedają taki lek do krajów rozwijających się, gdzie przecież bez przerwy brakuje środków farmaceutycznych3. Rynek zbytu rządzi się swoimi prawami. WHO szacuje, że w tych rejonach świata nawet jedna trzecia medykamentów może być wprowadzona do sprzedaży bez stosownych pozwoleń.
10. Nasz organizm również wytwarza broń przeciw drobnoustrojom
W ludzkim ciele bez przerwy powstają substancje zdolne do zabijania zarazków. Zalicza się do nich m.in. łzy, ślinę i mocz. Niewiele osób zdaje sobie sprawę z tego, jak ważną funkcję pełnią one w naszym organizmie.
ŁZY. Oczy są celem ataków drożdżaków oraz takich bakterii jak pałeczka ropy błękitnej, gronkowiec złocisty i dwoinka zapalenia płuc. Ponadto wyjątkowo łatwo przenieść na nie wirus opryszczki wargowej (HSV1). Dlatego właśnie we łzach znajdują się substancje zwalczające drobnoustroje.
Jedną z nich jest lizosom, który skutecznie powstrzymuje inwazję drożdżaków, a nawet może chronić organizm przed atakiem wirusa HIV! Dwie inne substancje, laktoferyna i lipokalina, wiążą nadmiar żelaza w organizmie oraz utrudniają bakteriom jego absorpcję. Żelazo jest pożywką dla wielu patogennych szczepów - pozbawione go, umierają. Wreszcie we łzach znajdują się przeciwciała znane jako immunoglobuliny A (IgA), produkowane głównie przez limfocyty B. Otaczają one bakterie filmem łzowym i uniemożliwiają im zagnieżdżanie, a także ułatwiają usunięcie patogenów z oka12.
ŚLINA. W jej skład również wchodzą immunoglobuliny typu A, które w tym przypadku chronią zęby przed bakteriami wywołującymi próchnicę. W ślinie znajduje się także laktoferyna utrudniająca patogenom pobieranie z komórek gospodarza jonów żelaza, niezbędnych im do przeżycia. Jej kolejnym ważnym składnikiem jest peroksydaza, która indukuje proces fagocytozy, czyli pochłaniania przez białe krwinki niebezpiecznych mikroorganizmów13,14.
MOCZ. Mimo że znajduje się w nim wiele rozmaitych składników, to tylko mocznik wykazuje silne działanie przeciwbakteryjne, co udowodniono w badaniu przeprowadzonym w nowojorskim Hospital-Cornell Medical Center15. I chociaż większość z nas postrzega mocz jako zbyteczny płyn, który musi być wydalony z organizmu dla naszego zdrowia, niemieckim naukowcom udało się w 2012 r. wykazać, że aplikowanie mocznika na zakażone gronkowcem złocistym miejsca na skórze działa leczniczo16.
Co dalej?
Większość przedstawionych w tym artykule informacji nie napawa optymizmem: antybiotyki są odpowiedzialne za wyniszczenie flory bakteryjnej jelit, wywoływanie niedoborów witaminowych, zakażenia groźnymi drobnoustrojami i zwiększanie oporności bakterii na dostępne terapie. Nie oznacza to jednak, że antybiotyki to samo zło. Zdarzają się sytuacje, kiedy ich zastosowanie jest jedynym rozwiązaniem. Ale nie przeceniajmy tych leków. Istnieje wiele innych substancji bakterio-, grzybo- i wirusobójczych, którymi możemy z powodzeniem je zastępować. Piszemy o nich w innych artykułach.
Tekst: Julia Cember
Bibliografia
- The Journal of Antibiotics 71, 4-14 (2018) doi:10.1038/ja.2017.117
- Nat Rev Microbiol. 2010 Jun; 8(6): 423-435. doi: 10.1038/nrmicro2333
- Microbiol Mol Biol Rev. 2010 Sep; 74(3): 417-433. doi: 10.1128/MMBR.00016-10
- goo.gl/y81jyZ
- goo.gl/EMx8Mt
- Biochemical and Biophysical Research Communications Volume 453, Issue 2, 17 October 2014, Pages 254-267 https://doi.org/10.1016/j.bbrc.2014.05.090
- Życie Weterynaryjne, 2013; 88(2), goo.gl/tMav5c
- ScientificWorldJournal. 2012; 2012: 930849. doi: 10.1100/2012/930849
- goo.gl/W1XvgJ
- Farm Pol, 2009, 65(3): 209-213, goo.gl/uzCDsY
- goo.gl/Dehw6P
- Exp Eye Res. 2013 Dec; 117: 10.1016/j.exer.2013.07.014. doi: 10.1016/j.exer.2013.07.014
- J Dent Res. 1987 Feb;66(2):475-9.
- Acta Odontol Scand. 1998 Oct; 56(5):250-6.
- J Clin Invest. 1968 Oct; 47(10): 2374-2390. doi: 10.1172/JCI105921
- J Invest Dermatol. 2012 Jun; 132(6): 1561-1572. doi: 10.1038/jid.2012.42

 Nasze magazyny
Nasze magazyny